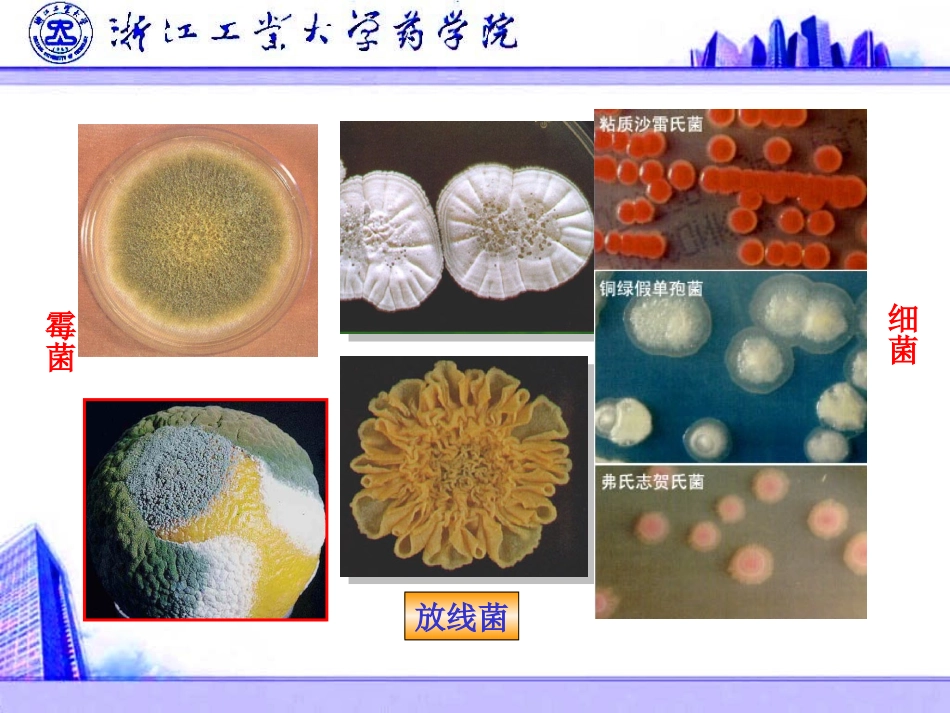
第二章 放线菌_第3页

第二章放线菌第一节放线菌的形态与结构第一节放线菌的形态与结构因其在固体培养基上呈辐射状生长而得名因其在固体培养基上呈辐射状生长而得名,,有特殊的有特殊的土霉味土霉味
在形态上具有分枝状菌丝、菌落在形态上具有分枝状菌丝、菌落形态与霉菌相似,以孢子进行繁殖
形态与霉菌相似,以孢子进行繁殖
具有菌丝,以孢子进行繁殖,革兰氏染色具有菌丝,以孢子进行繁殖,革兰氏染色呈阳性的一类原核微生物
呈阳性的一类原核微生物
霉菌细菌放线菌结构特点结构特点单细胞,大多由分枝发达的菌丝组成;菌丝直径与杆菌类似,约1m;细胞壁组成与细菌类似,革兰氏染色阳性(少数阴性);细胞的结构与细菌基本相同,按形态和功能可分为营养、气生和孢子丝三种
一、菌丝一、菌丝基内菌丝(一级菌丝,营养菌丝)气生菌丝(二级菌丝)孢子丝(繁殖菌丝)(一)基内菌丝(一)基内菌丝(二)气生菌丝(二)气生菌丝(三)孢子丝(三)孢子丝(一)放线菌与细菌的比较(一)放线菌与细菌的比较四、放线菌在微生物中的分类地位四、放线菌在微生物中的分类地位(二)放线菌与真菌的比较(二)放线菌与真菌的比较特征放线菌真菌细胞核无核膜,核仁有真正的细胞核菌丝体无隔膜,单细胞有隔,多细胞生物孢子大小1μm几十μm细胞壁肽聚糖几丁质、纤维素等噬菌体敏感性易收噬菌体侵染不易抗生素敏感性敏感不敏感酸碱度要求中性偏酸性鞭毛和细菌相似有尾鞭和茸鞭繁殖方式无性繁殖有性繁殖和无性繁殖第二节放线菌的繁殖第二节放线菌的繁殖一、放线菌的菌落特征一、放线菌的菌落特征放线菌的菌落介于细菌和霉菌之间,一般为圆形,表明光滑,或有皱褶、毛状、绒状或粉状,菌落较小,略大于细菌,比真菌菌落小
繁殖方式无性孢子细菌的芽孢是休眠体,而放线菌的孢子是繁殖体分生孢子孢囊孢子二、放线菌的繁殖方式及生活史二、放线菌的繁殖方式及生活史菌丝断裂常见于液体培养中,工业发酵生产抗生素时都以此法大量